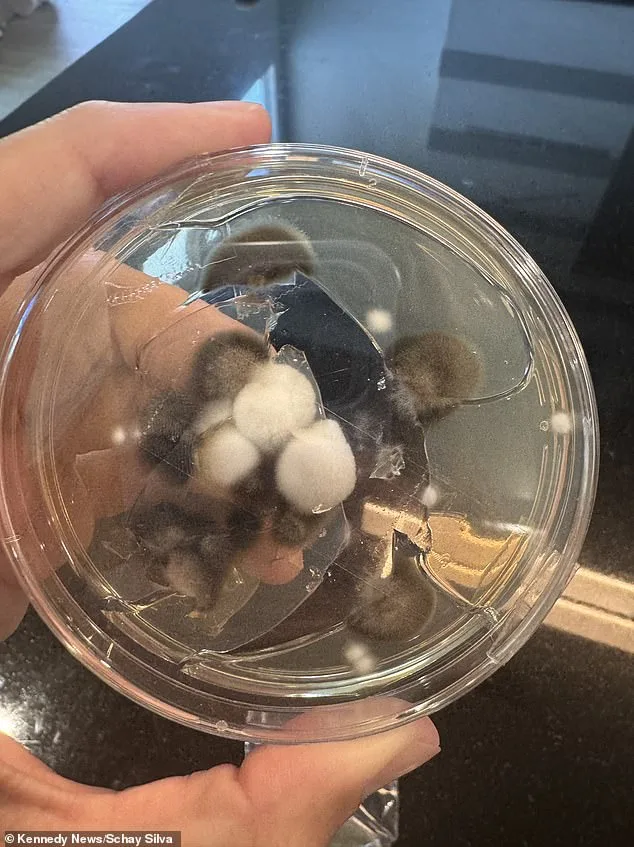
Three Years of Misdiagnosis: MRI Reveals Schayene Silva's Kidney Cancer

Three Years of Misdiagnosis: MRI Reveals Schayene Silva's Kidney Cancer

Schayene Silva's journey began with the excitement of moving into a new home in February 2022. What seemed like a fresh start quickly turned into a nightmare as she began experiencing persistent heartburn, relentless coughing, and episodes of vomiting. Her first visit to a doctor yielded a dismissive response: 'It's just gas.' The advice left her frustrated but resigned, as the symptoms refused to subside. Over the next three years, Silva would consult seven more physicians, each offering the same diagnosis—digestive issues—despite the pain growing more severe and unrelenting.

In October 2024, after enduring years of uncertainty, Silva's eighth doctor finally ordered an MRI scan. The results revealed a mass on her left kidney, later identified as Stage 1 clear cell renal carcinoma (ccRCC), the most common form of kidney cancer in the United States. The diagnosis shattered her world. At 38, with two young children, she was told by some doctors that her age made the condition 'unusual,' and others offered no explanation beyond 'bad luck.'

The surgery to remove the tumor in April 2025 marked the beginning of a new chapter, but Silva was determined to understand the root cause. Her research led her to investigate her home for mold, a known source of toxins linked to organ damage and cancer. Initial tests came back clean, but a closer inspection of her ice machine revealed a shocking discovery: it was 'covered in mold.' Further testing confirmed she had ten times the normal level of Ochratoxin A in her body, a toxin produced by Aspergillus and Penicillium molds. The World Health Organization has long associated Ochratoxin with kidney damage, immune system disruption, and developmental risks.

Silva described the emotional toll of her diagnosis: 'All I could do was cry. For weeks I was crying, but then I had to pick myself up.' Her determination to find answers led her to confront the invisible threat in her home. Mold, she learned, can thrive in high-moisture areas like ice machines within days, often before visible signs appear. The most dangerous molds, such as black mold, release mycotoxins that trigger inflammation, immune responses, and long-term health risks. In Silva's case, the Ochratoxin A in her system had likely contributed to the kidney damage that led to cancer.

Kidney cancer, which affects approximately 80,000 Americans annually, is the seventh-most common cancer in the U.S. While most cases are linked to aging, smoking, or alcohol use, emerging research suggests environmental toxins like mold may play a role. Silva's experience highlights a growing concern: the invisible dangers lurking in homes. The National Cancer Institute notes that only 6% of kidney cancer patients are diagnosed before age 45, making her case an outlier—and a cautionary tale.

Today, Silva is cancer-free, her symptoms like heartburn and nausea significantly reduced after removing the contaminated ice machine. She credits her recovery to persistence and the power of the body to heal once exposure to toxins ends. 'I wouldn't accept bad luck,' she said. 'I'm very lucky.' Her story underscores the importance of vigilance in home environments and the need for medical professionals to consider environmental factors in complex cases. For Silva, the battle against cancer was not just a personal fight—it became a mission to raise awareness about the hidden risks of mold and the importance of early detection.
Photos